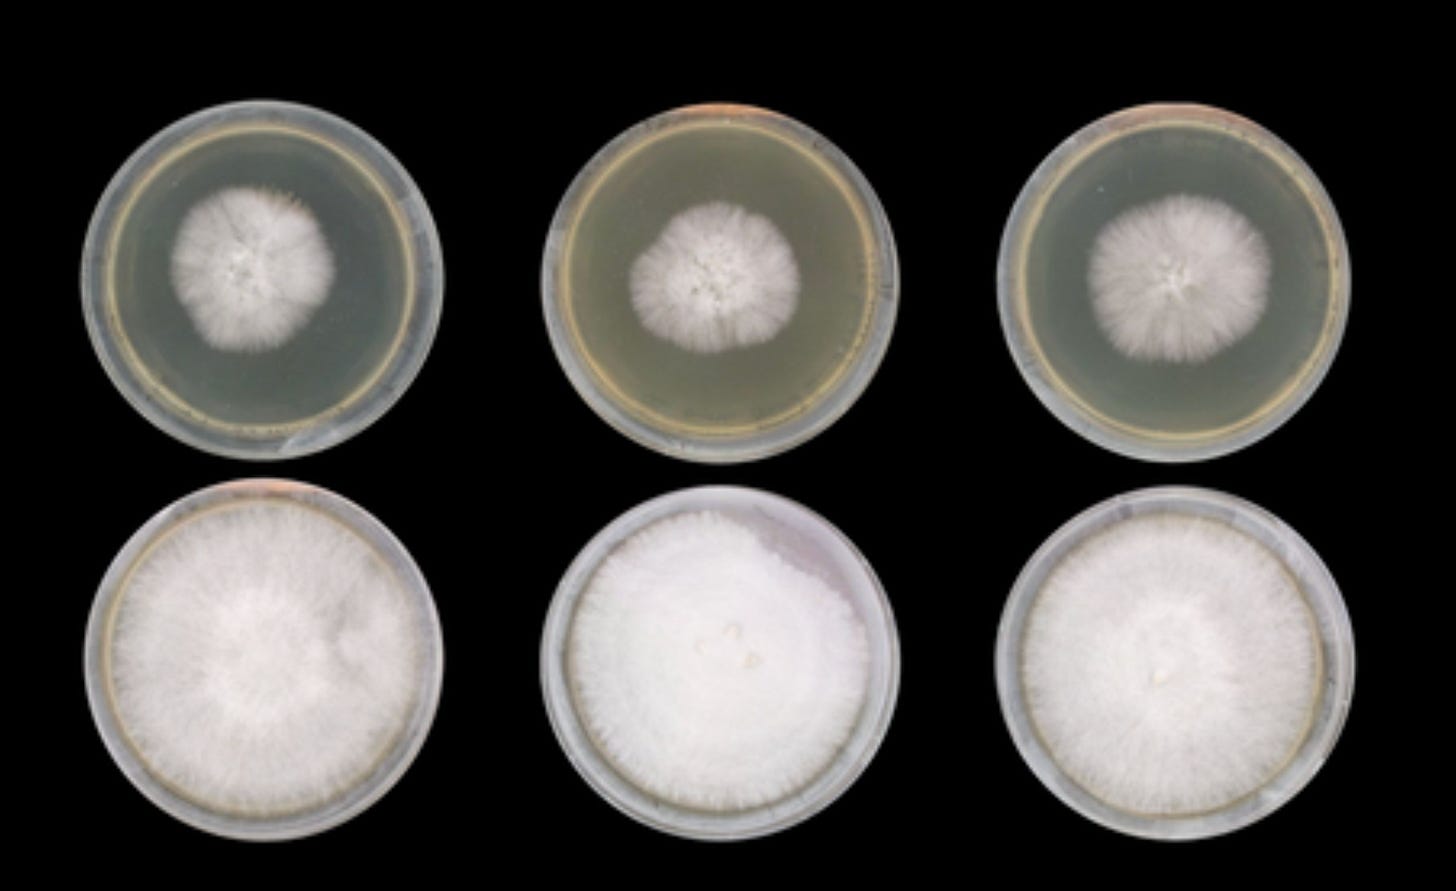

Mushrooms 'Sing'
Mushroom Music 30th November, London. Join us for all things fungi - photography, film screenings, talks, psychedelic music experience, mushroom coffee, biosonification workshops and more
A few years ago, I was commissioned to create a composition for Glastonbury festival’s Mycelium Pavilion. I used the bioelectricity from a range of fungi to create the piece, which was played on loop for the duration of the festival. Like an ever growing mycelial web, the ‘hypae’ generated from this installation set me on a path that lead to dozens of performances, talks and demonstrations of this ‘mushroom music’, culminating in the release of our Mycorrhizal Fungi EP, a multi-sensory vinyl record (with smell, light and amazing artwork by Jananicole), the first release on A State Of Flo records, and its release party at EartH in London, which saw 700 people cram in to experience a live rendition of the work.
Since then, the fungi zeitgeist shows not sign of abating and I’m excited that for the first time, we switch our focus at Plants Can Dance to ‘Mushrooms Sing’.
Mushroom Music - 30th November, Hideout, East London
I’ve put together an exciting line up of workshops, films, talks, photographs and music that cover so many topics highlighting the power of fungi. Needless to say but if you know anyone that is interested in mushrooms - please forward this to them to help us spread the word!
Here’s what we have planned:
🍄 Mushroom Biosonification Workshop (3-5pm) -
Kicking off at 3, we’ll explore a variety of different devices that are available for making bioelectrical music: PlantWave, the new Pocket Scion, MIDI Spad etc, and a full modular synth set up that we use during our mushroom music performances. Learn how to create your own compositions using bioelectrical signals and living organisms.
🍄 2 x Short Film Screenings (5-6pm) -
Lonely Mushroom will be released next year but has been winning awards at a variety of film festivals in 2025 including Best Exeperimental Short at the Global Film Awards. I was commissioned to compose the sound track for the closing credits (paid subscribers can hear this below. We’ll be joined for a Q&A with Director Dan Blackwell.
Underground Sound is a short film by UWE Bristol student Somes Huwiler. She spent a chunk of time with me over the course of this year, following my biosonification practise.
🍄 Zahra Coultard’s work with frequency and fungi (6pm)
I spent some time working with ecological artist Zahra Lucinda Coultard earlier this year. Entitled ‘Sound For the Soil’, she explored the affect of playing specific frequencies of sound to monitor the growth rates of fungi. The results are fascinating and she’ll present her findings on the 30th.
🍄 All Thing Fungi’s Max Mudie fungi photography and talk (6.30pm)
Comatrichia © Max Mudie
Max is the Co founder of All Things fungi festival and renowed fungi photographer, gaining him recognition with international platforms and magazines. His deep dive into mycology means he’s found and identified hundreds of species, he’s contributed to the Darwins tree of life project at Kew Gardens and is an active member of the Sussex Fungus group. Last year, he was invited to study Fungi in Barbados as part of Mycobim. This year, he will be leading forays and Macro workshops in Bhutan.
He’ll be presenting some of his work and talking us through his process.
🍄 Imperial Colleges Centre for Psychedelic Research - update on the current research (7pm)
We’ll also explore the psychedelic side of fungi with a talk on Imperial’s College’s work using psilocybin (synthetic magic mushrooms) to treat a range of mental health conditions. I’ve been involved with curating music for two trials, most recently one that is focussed on helping gambling addicts. We’ll talk through the process and will hopefully have research lead James B Close available to answer any questions.
🍄 Flow Brew - Functional mushroom coffee experience (all day)
I’ve been working with Simon Bateman from functional mushroom company Flow Brew all this year. Together we’ve hosted several ‘Live In Flow’ mushroom meditation events - where we treat the senses to a mushroom taste, sound and breathwork experience. Simon will be providing some samples of Flow Brew coffee to taste and purchase.
🍄 Psychedelic Dj set with music curated for the psychedelic therapy trials (7.30pm-10pm)
We’ll conclude things with a DJ set where I’ll play some music curated for the psychedelic trials. I did this at the Watching Trees festival earlier this year and wrote about it here:
TICKETS
It’s a totally packed line up and there are some early bird tickets still available for £11. Grab them HERE
Paid content below for subscribers only: